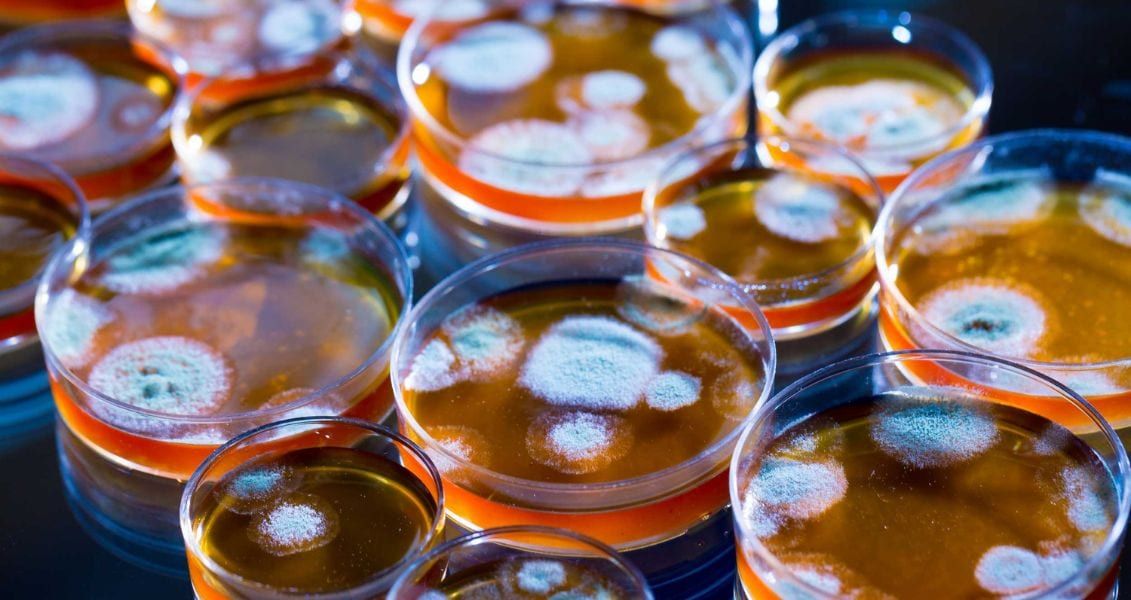
День народження пеніциліну нагадує про несподівану природу наукових відкриттів і про те, що одне спостереження може змінити хід історії. Він підкреслює важливість допитливості, ретельного спостереження і прагнення до знань для поглиблення людського розуміння і добробуту

В цей день народилися американська актриса Лілі Рейнхарт та український композитор-пісняр Анатолій Сердюк - свята, церковні та народні традиції
У п'ятницю, 13 вересня, православна церква шанує пам'ять святого Корнилія. Іменини сьогодні святкують Олександр, Валеріан, Єрофій, Ілля, Леонтій, Лук'ян, Микола, Петро, Стефан, Юліан.
13 вересня відзначають День народження пеніциліну - це випадкове відкриття, що зробило революцію в медицині. 13 вересня 1928 року світ став свідком доленосної події в історії медицини - випадкового відкриття пеніциліну Олександром Флемінгом. Цю дату часто відзначають як "день народження" пеніциліну, що знаменує початок революційної епохи в медицині.
Олександр Флемінг, шотландський бактеріолог, проводив дослідження в лікарні Святої Марії в Лондоні, коли натрапив на цю революційну знахідку. Він вивчав бактерії стафілокока і залишив чашку Петрі з бактеріями на своєму лабораторному столі без кришки, коли поїхав у відпустку. Повернувшись, він помітив дещо дивовижне: на чашці розвинулася пліснява під назвою Penicillium notatum, яка ефективно пригнічувала ріст бактерій, що її оточували. Гостра спостережливість Флемінга привела його до усвідомлення потенціалу цього відкриття. Він визначив, що пліснява виділяла речовину, яка мала антибіотичні властивості, здатну вбивати шкідливі бактерії, не завдаючи шкоди людським клітинам. Це ознаменувало народження пеніциліну, першого справжнього антибіотика, і проклало шлях до медичної революції.
Вплив пеніциліну на охорону здоров’я неможливо переоцінити. До його відкриття бактеріальні інфекції часто були небезпечними для життя, а можливості лікування були обмеженими. Поява пеніциліну змінила медицину, надавши потужний інструмент для боротьби з бактеріальними інфекціями. Його широке застосування під час Другої світової війни ще більше підкреслило його потенціал для порятунку життя, лікування поранених солдатів і порятунку незліченної кількості життів.
Відкриття пеніциліну заклало основу для розробки антибіотиків, які відтоді стали наріжним каменем сучасної медицини. Вони дозволили успішно лікувати широкий спектр інфекцій, від звичайних недуг до серйозних захворювань. Однак надмірне і неправильне використання антибіотиків також викликало занепокоєння щодо антибіотикорезистентності, що підкреслює важливість їх відповідального застосування.

13 вересня у світі відзначається Міжнародний день шоколаду або International Chocolate Day. Національна асоціація кондитерів США визначила цей день Міжнародним днем шоколаду, що збігається з датою народження Мілтона С. Херші (Milton Snavely Hershey - 13 вересня 1857 року). Мілтон Снавлі Херші - видатний американський шоколатьє, підприємець і філантроп.
Здобувши освіту в кондитерській галузі, Херші досяг значних успіхів, впровадивши інновації у виробництво карамелі, використовуючи в процесі свіже молоко. Він заснував компанію Lancaster Caramel Company, яка не тільки досягла значних міжнародних продажів, але й пізніше була продана Херші для фінансування нового підприємства - нового підприємства, орієнтованого на масове виробництво молочного шоколаду, раніше ексклюзивного делікатесу, що був предметом розкоші.
У 1900 році перші батончики Hershey з’явилися на ринку, зачарувавши споживачів настільки, що Херші зміг розпочати будівництво власного фірмового містечка, названого влучно - Херші, у Пенсильванії.
Під час Другої світової війни компанія Hershey’s розробила спеціалізовану нетанучу шоколадну плитку, призначену для військ, дислокованих за кордоном. Ця інновація продемонструвала відданість компанії своїй справі. Сьогодні The Hershey Company, яку часто називають Hershey’s, є одним з найвідоміших виробників кондитерських виробів у світі, що продовжує спадщину Мілтона Сневелі Херші, яка полягає в інноваціях, філантропії та солодких насолодах. Ця шоколадна подія вийшла за межі кордонів США, її гучно святкують в Німеччині, Швейцарії (тут, до речі, шоколаду споживають більше, ніж деінде) та в інших країнах ЄС і світу.

13 вересня відзначається День позитивного мислення або Positive Thinking Day, ініціатором запровадження якого став американський підприємець у 2003 році. Позитивним мисленням не можна назвати відчуття, яке з’являється у людини в періоди перемог, гарних новин чи приємних подій. В таких ситуаціях бути оптимістом достатньо легко. Позитивне мислення має прямий зв’язок зі здатністю підтримувати в собі надію та зацікавленість попри події, позитивні чи негативні.
Стреси та труднощі у повсякденному житті іноді наповнюють мислення песимізмом. Це неофіційне свято пропагує ідею про те, що негативні думки приносять більше шкоди, ніж користі, вони виснажують, відбирають енергію. Якщо ви не знаєте, як провести цей день, почніть з початку. Прокидайтеся з позитивом, задавайте тон майбутньому дню зранку, спілкуйтеся з позитивними людьми, читайте радісні новини та книги, частіше посміхайтесь, демонструйте вдячність за прості речі та будьте добріші до інших.

13 вересня своє професійне свято відмічають стилісти - перукарі - День перукаря. Це саме ті фахівці, хто робить ваше волосся здоровим та красивим, а також колористи, барбери та інші спеціалісти. Термін "перукар" бере своє коріння від німецького поняття, яке визначає спеціаліста по роботі з перуками. Цікаво, що в Німеччині цей термін давно не вживається та вважається застарілим.
Ще у Давньому Єгипті існували подібні послуги. Саме ця країна вважається батьківщиною перших професійних майстрів з укладання зачісок. Не відстала і стародавня Греція, де для цих послуг спеціально навчали рабів.

13 вересня православна церква вшановує пам'ять святого Корнилія. Святий Корнилій був римським сотником, який жив у I столітті. Він був першим язичником, який прийняв християнство після того, як йому з'явився ангел і сказав, що Бог сподобався його молитві та милостині. Ангел також наказав запросити апостола Петра, щоб той навчив його слова Божого. Петро прийшов у дім Корнилія в Кесарії та проповідував йому про Ісуса Христа.
Під час проповіді Святий Дух зійшов на Корнилія та всіх, хто був із ним. Петро тоді хрестив його в ім'я Отця і Сина та Святого Духа. Таким чином, Корнилій став першим язичником, який прийняв віру в Христа.
Пізніше Корнилій став єпископом Скеврополя (сучасний Скевра у Греції) і сповіщав Євангеліє серед місцевих жителів. Він також допомагав апостолу Павлу у його місіонерській діяльності. За легендою, коли Корнилія привели до язичницького храму з вимогою принести жертву ідолам, останні розсипалися разом із храмом через молитву святого. Реакція на це язичницького правителя була стандартною - святого Корнилія мали страчувати наступного дня. Але Бог захистив свого слугу і дозволив йому померти природною смертю у глибокій старості.
За старих часів у цей день збирали коренеплоди - моркву, буряк, пізню картоплю, ріпу та обов'язково готували страви з них - вважалося, що вони принесуть мир у сім'ю.
13 вересня 1931 р. - Барбара Бейн - американська актриса. Вона найбільш відома за роллю Сіннамон Картер у класичному телесеріалі "Місія нездійсненна", в якому вона знімалася з 1966 по 1969 рік.

13 вересня 1944 р. - Жаклін Біссет - британська кіноактриса, відома за ролями у фільмах 1960-80-х років, серед яких такі значні, як "Американська ніч" Трюффо і "Безодня" Єтса.

13 вересня 1967 р. - Анатолій Васильович Сердюк - український композитор-пісняр, співак, громадський діяч, журналіст. На всеукраїнську естраду співак і композитор вийшов у серпні 1991 року, ставши призером Всеукраїнського фестивалю "Червона рута" з власною піснею на вірш Д.Павличка "Вставай, Україно!".

13 вересня 1968 р. - Емма Софія Крістіна Віклунд - шведська фотомодель і кіноактриса, найвідоміша за головною роллю комісара поліції Петри у фільмі "Таксі" і його продовженнях "Частина 2", "Частина 3" і "Частина 4".

13 вересня 1996 р. - Лілі Плін Рейнхарт - американська актриса. Найбільш відома за роллю Бетті Купер у телесеріалі "Рівердейл".

Підписуйтесь на наш Telegram-канал, щоб не пропустити важливих новин. Підписатися на канал у Viber можна тут.